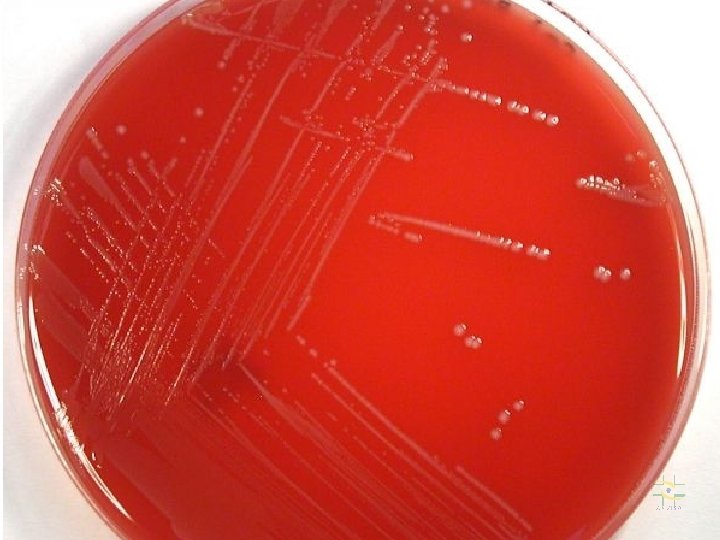
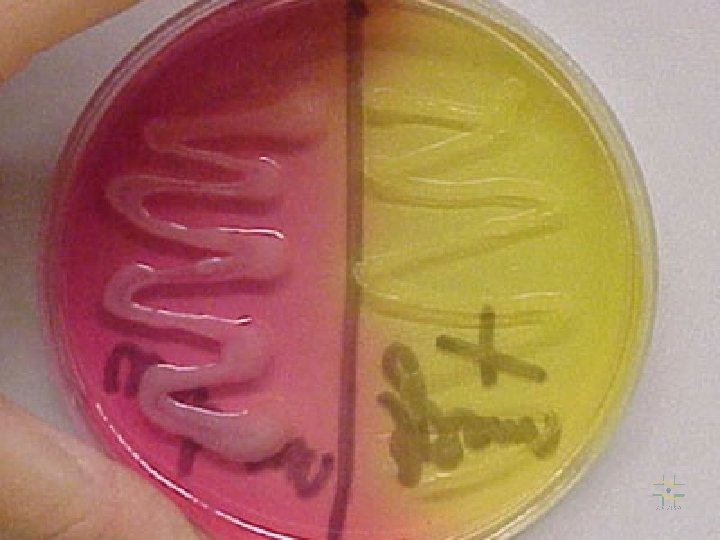

Enterococcus identificao e susceptibilidade a antimicrobianos e outros

Enterococcus identificação e susceptibilidade a antimicrobianos (e outros gêneros de cocos catalase negativos - relacionados) Dra. Lúcia Martins Teixeira Instituto de Microbiologia UFRJ

Enterococcus Gênero Enterococcus: habitat Enterococcus : patogenicidade Infecções Enterocócicas Riscos de aquisição de infecção enterocócica Isolamento de enterococos identificação de enterococos e bactérias relacionadas Características Fenotípicas de Cocos Gram-Positivos Catalase-Negativos Key tests Estudos Taxonômicos em Enterococcus e Gêneros Relacionados Resistência de Enterococcus a Antimicrobianos Enterococcus Emergência de novos perfis e mecanismos de Resistência a Antimicrobianos Resistência a Níveis Elevados Antimicrobial resistance among enterococci causing hospital infections Resistência a Glicopeptídeos em Enterococcus Testes de Susceptibilidade aos Antimicrobianos continua índice

Métodos de tipagem Métodos de triagem Interpretação de testes Novos antimicrobianos para o tratamento de infecções por VRE Isolamento de VRE a partir da Microbiota Intestinal Estudos epidemiológicos nas infecções enterocócicas Métodos de tipagem de enterococos Ocorrência de resistência a níveis elevados de aminoglicosídeos entre enterococos de origem clínica humana Resistência à Vancomicina em Enterococos no Brasil Emergências Cocos Gram-Positivos Intrinsicamente Resistentes a Vancomicina Características Fenotípicas de Cocos Gram-Positivos Catalase-Negativos Infecções por Microrganismos Characteristics of patients with urinary tract infections caused by Leuconostoc pseudomesenteroides Clinical sources and diagnosis and/or infections associated with 72 Pediococcus isolates índice

Enterococcus O gênero inclui bactérias anteriormente classificadas como Streptococcus do grupo D Streptococcus faecalis Streptococcus faecium Gênero Enterococcus (1984) Enterococcus sp. em cultura de sangue

Enterococcus Histórico • 1899, Thiercelin: diplococos Gram +, de origem intestinal • 1906, Andrewes & Holder: Streptococcus faecalis • 1919, Orla-Jensen: Streptococcus faecium • 1933, Lancefield: classificação sorológica estreptococos • 1937, Sherman: piogênicos, láticos, enterococos e viridans • 1970, Kalina: proposta da criação do gênero Enterococcus • 1984, Schleifer & Kilpper-Balz: criação do gênero Enterococcus através de estudo de DNA • 1984 -. . . : inclusão de várias espécies no gênero

Gênero Enterococcus E. faecalis E. faecium E. avium E. casseliflavus E. durans E. gallinarum E. malodoratus E. hirae E. mundtii Schleifer & Kilpper-Bälz 1984 Collins et al. 1984 Farrow & Collins 1985 Farrow, Collins & Jones 1986

Gênero Enterococcus E. faecalis* E. faecium* E. avium* E. casseliflavus* E. durans* E. gallinarum* E. malodoratus E. hirae* E. mundtii* E. raffinosus* E. solitarius E. pseudoavium E. cecorum E. columbae E. saccharolyticus E. seriolicida E. dispar E. sulfureus E. flavescens E. asini E. haemoperoxiidus E. moraviensis E. villorum E. porcinus E. ratti E. gilvus E. pallens E. phoeniculicola E. canis 3 Novas Espécies. . . . Schleifer & Kilpper-Bälz 1984 Collins et al. 1984 Farrow & Collins 1985 Farrow, Collins & Jones 1986 Collins et al. 1989 Williams et al. 1989 Devriese et al. 1990 Rodrigues & Collins 1990 Kusuda et al. 1991 Collins et al. 1991 Martinez-Murcia & Collins 1991 Pompei et al. 1992 de Vaux et al. 1998 Svec et al. 2001 Vancanneyt et al. 2001 Teixeira et al. 2001 Tyrrell et al. 2002 Law-Brown & Meyers, 2002 De Graef et al. 2002 Carvalho et al. 2004

Enterococcus resistente: habitat • Trato gastrintestinal • Trato geniturinário • Cavidade oral • Solo, água, vegetais e alimentos • Sobrevive em ambientes contaminados

Enterococcus oportunista : patogenicidade PATÓGENO HOSPITALAR OPORTUNISTA EMERGENTE E. faecalis : 80 -90% das infecções em seres humanos E. faecium : segundo (5 -10%), exceto em caso de surtos • • Infecções do trato urinário (15%) Infecções de feridas Bacteremias (7%) [Endocardites (15 -20 %)] Infecções pélvicas, intra-abdominais Obs: Aparece no ambiente hospitalar: 1960

Infecções Enterocócicas Origem Endógena Exógena Aquisição/ Transmissão Comunitária Hospitalar

Enterococcus: patogenicidade FATORES/MECANISMOS DE VIRULÊNCIA Aderência (hemaglutininas; substância de agregação) Citolisinas (hemolisina/bacteriocina) Invasão (substância de agregação; translocação intestinal) Lise dependente do complemento Resistência à lise pelos neutrófilos Resistência a antimicrobianos

Riscos de aquisição de infecção enterocócica Fatores relacionados com o microrganismo • Distribuição ubiquitária fontes endógena exógena (comunitária e hospitalar) • Marcadores importantes - resistência a phs e temperaturas variados - capacidade de adquirir resistência aos antimicrobianos • Emergência de novos padrões de resistência - resistência a níveis elevados de: aminoglicosídeos, b-lactâmicos, glicopeptídeos • Favorecimento da patogenicidade - vantagens seletivas : - sobrevivência - disseminação

Riscos de aquisição de infecção enterocócica Fatores relacionados com o hospedeiro • doença de base grave • hospitalização prolongada (uti; unidades renais, oncológicas) • cirurgia (cardiovascular, abdominal) • cateterização (urinária, venosa) • terapia antimicrobiana prolongada : Cefalosporinas Aminoglicosídeos Fluoro-quinolonas Glicopeptídeos Fatores Relacionados com o Ambiente Hospitalar • transmissibilidade • pressão seletiva pelo uso de antimicrobianos

Isolamento de enterococos Seleção do espécime clínico Coleta Transporte Semeadura: Meios Simples Meios Enriquecidos Meios Seletivo-Indicadores

identificação de enterococos e bactérias relacionadas

Características Fenotípicas de Cocos Gram. Positivos Catalase-Negativos gênero van gás pyr lap be nacl cresc. a: 10 oc 45 oc Cadeias Streptococcus Enterococcus Vagococcus Lactococcus Leuconostoc Weissella Abiotrophia Globicatella S S/R S S R R S S + + - + + + V V - + + V V + + + + V - V + (-) V V - a/b/n a/n a/n a a Agrupados e Tetrades Pediococcus Tetragenococcus Aerococcus Gemella Helcococcus Alloiococcus Dolosigranulum Facklamia Ignavigranum R S S S S - + + + + + V + - V + + + + - - a a/n n n a Motilidade hem

Identificação de enterococos Métodos convencionais Identificação presuntiva • Observação da morfologia colonial e padrão de hemólise • Características morfotintoriais • Avaliação fisiológica preliminar: - Catalase - BE - Na. Cl 6, 5% - LAP - PYR - Vanco Caracterização fisiológica • • • Testes convencionais (bioquímicos e sorológicos) Sistemas rápidos (API 20 S, Rapid Strep) Sistemas automatizados (VITEK, Micro. Scan) Pesquisa de pgmento Motilidade

Características fenotípicas de enterococcus e gêneros relacionados Espécies MAN SOR ARG ARA SBL RAF TEL MOT PIG SAC PIR MGP Grupo I E. avium E. malodoratus E. raffinosus E. pseudoavium E. saccharolyticus + + + + + - - - + + + + + - + + +* + + + - +* + + + v v v - v + + -* - +* +* +* + - +* v +* + + v - + + Grupo II E. faecalis L. garvieae E. faecium E. casseliflavus E. mundtii E. gallinarum

Características fenotípicas de enterococcus e gêneros relacionados Espécies MAN SOR ARG ARA SBL RAF TEL MOT PIG SAC PIR MGP - - v + - - - + + Grupo III E. durans E. hirae E. dispar - - + + + - - + - + + - - + - + + + - + Grupo IV E. sulfureus E. cecorum Grupo V E. columbae V. fluvialis

Key tests, including methyl a -D- glucopyranoside and efrotomycin tests, for the identification of the group II enterococcal species Species MOT PIG MGP EFRO E. faecalis - - - R E. faecium - - - S + a + R - + - S +a - + R E. casseliflavus E. mundtii E. gallinarum a + a Occasional variant reaction.

Identificação de enterococos Métodos moleculares • Perfis de proteínas totais • Sondas p/ genes específicos. Ex. Enterococcus Gen. Probe • PCR para: • D-alanil-D-alanina ligase (E. faecalis e E. faecium) • van. C-1 (E. gallinarum) • van. C-2/3 (E. casseliflavus, “E. flavescens”) • (ITS-PCR) entre 16 S e 23 S r. RNA • Sequenciamento dos genes 16 S • Hibridização de DNA

Estudos Taxonômicos em Enterococcus e Gêneros Relacionados • Caracterização Fenotípica Convencional • Análise dos Perfis de Proteínas (SDS-PAGE) • Hibridização DNA/DNA • Seqüenciamento do genes 16 S r. RNA

Resistência de Enterococcus a Antimicrobianos Resistência Intrínseca • • • Aminoglicosídeos (níveis baixos) b-lactâmicos (valores de CIM relativamente elevados) Lincosaminas (níveis baixos) Trimetoprim-Sulfametoxazol (somente “in vivo”) Vancomicina (E. casseliflavus, E. gallinarum) Resistência adquirida (plasmídeos e transposons) • • Aminoglicosídeos (níveis elevados) • Estreptomicina: ribossômica / adenil-transferase • Gentamicina: acetil-transferase + fosfo-transferase b-lactâmicos (alteração das PBPs; produção de b-lactamases; tolerância) Glicopeptídeos ( Van. A, Van. B, Van. D, Van. E) Fluoroquinolonas Lincosaminas (níveis elevados) Macrolídeos Rifampicina Tetraciclinas

Enterococcus Emergência de novos perfis e mecanismos de Resistência a Antimicrobianos • Resistência a Níveis Elevados de Aminoglicosídeos • Resistência a Níveis Elevados de b-Lactâmicos • Resistência a Glicopeptídeos

Resistência a Níveis Elevados de Aminoglicosídeos CMIs > 2000 µg/ml : resistência ao sinergismo Mecanismos de resistência: (plasmídios/transposons): • Enzimas modificadoras de aminoglicosídeos (EMAS) AAC(6’)-Ie + APH(2’’)-Ia AAC(6’)-Ii APH(2’’)-Ib ; APH(2’’)-Ic ; APH(2’’)-Id APH(3’)-IIIa ANT(3’)-Ia ; ANT(4’)-Ia ; ANT(6’)-Ia • Alteração do sítio alvo (Resistência ribossômica/estreptomicina)

Resistência a Níveis Elevados de b-lactâmicos Modificação das proteínas ligadoras de penicilina (PBPs) • Amostras resistentes à penicilina (E. faecium) têm sido relatadas há décadas (CMIs 8 -64 µg/ml) • Amostras resistentes a níveis mais elevados têm sido relatadas com mais freqüência atualmente Produção de b-lactamase • 1981, 1 o relato de amostra produtora de b-lactamase • Gene tem localização plasmidial (associado a HLR-GE)

Antimicrobial resistance among enterococci causing hospital infections Source: National Nosocomial Infections Surveillance (NNIS) System Vancomycin-resistant enterococci 30 20 15 10 5 Non-Intensive Care Unit Patients 20 00 19 99 19 98 19 97 19 96 19 95 19 94 19 93 19 92 19 91 19 90 0 19 89 Percent Resistance 25 Intensive Care Unit Patients

Resistência a Glicopeptídeos em Enterococcus Fenótipo Van A Van B Van C CMI ( g/ml): Vancomicina Teicoplanina 64 - >1000 16 - 512 4 - >1000 0, 5 - 1 2 -32 0, 5 -1 Expressão Induzida Constitutiva Localização dos genes Plasmídeos Cromossomo Genótipo Produtos van. A D-Ala-D-Lac van. B D-Ala-D-Lac van. C D-Ala-D-Ser Espécies E. faecium E. faecalis E. avium E. durans E. mundtii E. casseliflavus. E. gallinarum E. casseliflavus

Resistência a Glicopeptídeos em Enterococcus Fenótipo Van D Van E Van G CMI (µg/ml): Vancomicina Teicoplanina 64 -128 4 -64 16 0, 5 Expressão Constitutiva Induzida ? Localização dos genes Cromossoma ? ? Genótipo van. D van. E van. G Produtos D-Ala-D-Lac D-Ala-D-Ser ? Espécies E. faecium E. faecalis E faecalis

Testes de Susceptibilidade aos Antimicrobianos TSA para Enterococcus • Importância da Aderência a Padronização Execução, Controle de Qualidade Interpretação • Importância de Manutenção Constante de Atualização no Tema • Importância de Avaliação Crítica dos Resultados

Métodos de triagem Interpretação dos resultados Gentamicina e Estreptomicina: > 1 colônia / cresc. em caldo = resistente O sinergismo obtido entre gentamicina ou estreptomicina e antimicrobianos de ação na parede (ampicilina, penicilina e glicopeptídeos) não ocorrerá. Vancomicina: >1 colônia = resistência presuntiva Realizar testes de motilidade e pigmento para distinguir espécies com resistência adquirida (Van. A e Van. B) daqueles com resistência intrínseca a níveis intermediários de vancomcina (E. gallinarum, E. casseliflavus)

Métodos de triagem Meio de cultura BHI Agar ou caldo suplementado com: • 500 µg /ml de Gentamicina (agar ou caldo) • 2000 µg /ml (agar) / 1000 µg/ml (caldo) de Estreptomicina • 6 µg /ml de Vancomicina (agar) Inóculo • Suspensão a partir de um crescimento de 18 -24 h com turvação padrão 0. 5 Mc. Farland (108 UFC/ml) • “Spot” de 10 ml na superfície do agar = 106 UFC/ml (genta e estrepto) • “Spot” de 1 -10 ml na superfície do agar = 106 UFC/ml (vanco) Incubação • • 24 h, 35 o. C, ar ambiente (Genta e Vanco) 24 -48 h, 35 o. C, ar ambiente (Estreptomicina)

Métodos de Triagem para a Detecção de Resistência a Níveis Elevados de Aminoglicosídeos (HLR-A) em enterococos Parâmetro Triagem Agar Triagem Caldo Disco Meio BHI agar BHI caldo MHA Antimicrobiano (conc. ) Gentamicina Estreptomicin 500 µg/ml 2000 µg/ml 500 µg/ml 1000 µg/ml 120 µg/ml 300 µg/ml Inóculo 106 CFU/spot 5 x 104 CFU/0. 1 ml 0. 5 Mc. Farland Incubação (h) 24 24 18 - 24 Leitura (Interpretação) > 1 colônia Qualquer crescimento > 10 mm = susceptível 7 -9 mm = intermediário < 6 mm = resistente

Métodos de triagem para a detecção de resistência a vancomicina em enterococos Parâmetro Triagem em Agar Difusão (disco) Meio BHI agar MHA Antimicrobianol (Concentração) 6 µg/ml 30 µg/ml Inóculo 105 - 106 CFU/spot 0. 5 Mc. Farland Incubação (h) 24 24 Leitura (Interpretação) > 1 colônia > 17 mm = susceptível 15 -16 mm = intermediário < 14 mm = resistente

Interpretação de testes de susceptibilidade para Enterococcus (métodos de difusão e de diluição: NCCLS, 2004; M 100 -S 14) Grupo Antimicrobianos Diâmetro(mm) S I R CIM ( g/ml) S R A Ampicilina (10 g) 17 - 16 8 16 A Penicilina (10 U) 15 - 14 8 16 B Vancomicina (30 g) 17 15 -16 14 4 32 Inv Teicoplanina (30 g ) 14 11 -13 10 8 32 C Eritromicina (15 g) 23 14 -22 13 0. 5 8 C Estreptomicina (300 g ) 10 7 -9 6 C Gentamicina (120 g ) 10 7 -9 6 C Tetraciclina (30 g ) 19 15 -18 14 4 16 U Ciprofloxacina (5 g) 21 16 -20 15 1 4

Grupos de Agentes Antimicrobianos que devem ser considerados em testes de rotina para Enterococcus

Novos antimicrobianos para o tratamento de infecções por VRE Quinupristin-Dalfopristin Associação de estreptogramina B + estreptogramina A (30: 70). Tratamento de infecções por E. faecium Van R Aprovado em Dez/1999 Linezolid oxazolidinona Aprovado em Abr/2000 Resistência tem sido documentada em amostras de origem humana e animal

Isolamento de VRE a partir da Microbiota Intestinal Swab Retal / Fezes 1 ml de salina estéril 100 l 1 ml de caldo Enterococcosel (BBL) Sem antimicrobiano Vancomicina 6 g/ml 24 - 48 hs / 35 o. C Caldos c/ cor preta TSA + 5% sangue de carneiro Colônias suspeitas Identificação a nível de espécie

Estudos epidemiológicos nas infecções enterocócicas • • • Aumento dos casos de infecção enterocócica Isolamento de amostras com padrões de resistência incomuns Atipia fenotípica (ex: E. Faecium, raf +, sbl + ou man -, sac -) surto ? • • Identificação a nível de espécie de todas as amostras Triagem da resistência origem ? Tipagem molecular • Clone único ? • multiclonal ?

Métodos de tipagem de enterococos Métodos convencionais • • • Biotipagem Resistotipagem Bacteriocinotipagem Fagotipagem Sorotipagem Métodos moleculares • Fenotípicos Análise dos Perfís de Proteínas Tot. Análise do Polim. Eletr. de Isoenz. • Genotípicos Análise dos Perfís Plasmidiais Análise do DNA cromossômico PFGE Ribotipagem Reação da Polimerase em Cadeia AP-PCR, RAPD-PCR, Rep-PCR, ITS-PCR, etc. . . Sequenciamento MLST

Ocorrência de resistência a níveis elevados de aminoglicosídeos entre enterococos de origem clínica humana Stern et al. , 1994 : 39% Merquior et al. , 1997 : 55% Carvalho, 1998 : 50% Mendonça, 1998: 43% % 60 50 40 30 Paula, 2000: 38, 5% 20 Mondino et al, 2003: 52, 2% 10 0 Presente estudo Merquior et al. , 1997 Stern et al. , 1994 Mendonça, 1998 Carvalho, 1998 Paula, 2000

Resistência à Vancomicina em Enterococos no Brasil 1996 - Curitiba E. faecium van. D 4 • Hemocultura de criança ( F ) portadora de anemia aplásica submetida a transplante de medula. MICs: Vanco = 256 µg/ml Teico = 4 µg/ml HLR-Ge/St 1997 - São Paulo E. faecium van. A • Adulto ( F ) com meningite • VRE tornou-se endêmico no hospital • Amostras de VRE passaram a ser detectadas em outros hospitais de São Paulo

Emergência de VRE Rio de Janeiro • Janeiro 2000 HU-PE / UERJ. Septicemia • Paciente (M 50 anos) com doença maligna hematológica e falência renal • VRE isolado de: • Sangue, fezes, pele e ulcera de decúbito do paciente índice • Fezes de outro paciente na mesma unidade (1/8 12, 5%) • Fontes ambientais (utensílio para banho: 1/16 - 6, 2%) • Caracterização: • Enterococcus faecalis van. A; HLR-Ge • MICs: Vanco > 256 µg/ml; Teico = 92 µg/ml

Emergência de VRE Rio Grande do Sul • Maio 2000 Hospital São Lucas / PUC • Disseminação inter-hospitalar • Enterococcus faecalis van. A • MICs: Vanco = 1024 µg/ml; Teico = 256 µg /ml • Perfis de PFGE relacionados entre si e a clones previamente encontrados

Ocorrências Recentes de VRE Rio de Janeiro: • HU-PE / UERJ - Enterococcus gallinarum van. A • Hospital da rede publica - E. faecalis • Hospital da rede privada - E. faecium van. A • Hospitais das redes publica e privada - E. faecium van. A Niterói: • HU-AP / UFF - Enterococcus faecalis van. A • Hospital da rede privada - E. faecium

Cocos Gram-Positivos Intrinsicamente Resistentes a Vancomicina : Patógenos Emergentes Enterococcus Leuconostoc Pediococcus

Características Fenotípicas de Cocos Gram -Positivos Catalase-Negativos Gênero VAN GÁS PYR LAP BE Na. Cl Cresc. a: MOT HEM 10 o. C 45 o. C Cadeias Streptococcus S - - + - - V V - a/b/n Enterococcus S/R - + + + V a/b/n Vagococcus S - + + + (-) V a/n Lactococcus S - + + + V + (-) - a/n Leuconostoc R + - - V V + V - a/n Pediococcus R - - + + V - + - a

Infecções por Microrganismos do Gênero Leuconostoc em Pacientes Residentes Rio de Janeiro Sexo, idade paciente M, 32 a F, 51 a Espécie identificada Espécimen clínico Aquisição Doença subjacente Fatores de risco L. pseudomesenteroides Sangue Hospitalar SIDA Uso de cefalo 3 a geração, SFT cateter IV L. pseudomesenteroides Cateter Hospitalar Artrite Cateter IV F, 50 a L. lactis Sangue Comunitária - F, 76 a L. citreum Sangue Hospitalar Insuficiência renal Prótese válvula cardiaca Uso de vanco e cateter IV M, 58 a L. pseudomesenteroides Sangue Hospitalar Insuficiência renal Uso de vanco e cateter IV

Characteristics of patients with urinary tract infections caused by Leuconostoc pseudomesenteroides Concn of Clinical organism in outcome urine CFU/ml Age (yr), sex Underlying conditions Previous therapy Associated symptoms 1 16, M Hydrocephalus and prolonged hospital stay Vanco and cephalosp Fever 5 x 105 Death 2 29, M Asthma, alcoholism and drug addiction None Dysuria and fever 5 x 105 Recovery 3 14, F Dysuria 3 x 105 Patient no. 4 5 18, F 37, F Renal transplantation Vanco and prolonged trimeth-sulfamet hospital stay Endometriosis and prolonged hospital stay Vanco and cephalosp Dysuria and fever 4 x 105 Not determined None Dysuria and fever 4 x 105 Recovery

Clinical sources and diagnosis and/or infections associated with 72 Pediococcus isolates Strains associated with different clinical conditions Clinical isolates P. acidilactici No. Condition(s) (no. of strains) Blood 28 Stool Peritoneal fluid 8 4 Abscess 3 Urine Wound Catheter 3 2 Bone CFS Liver biopsy Vaginal secretion Unknown Total 1 1 2 54 Congestive heart failure (1) endocarditis (1), septicemia (5), peritonitis (1), peptic ulcer (1), Hickman line infection (1), bone marrow transplant (1), cellulitis (1), unknown (16) Diarrhea (7), Unknown (1) Rectal carcinoma (1), fistula (1), colitis (1), peritonitis (1) Rectal carcinoma (1), Crohn’s disease (2) UTI (1), unknown (2) Entritis (1), unknown (1) Bone cyst Unknown Liver transplant Vaginitis P. pentosaceus No. Condition(s) (no. of strains) 4 Coronary artery disease (1) septicemia (1), unknown (2) 3 Diarrhea 1 Peritonitis 2 Unknown 2 Pneumoniae (1), unknown (1) 3 Abdominal surgery (1), coronary artery disease (1), unknown (1) 1 Bone infection 2 18

FLUXOGRAMA BGN Oxidase Lac + Ágar Mac Conkey Lac IAL E. coli Enterobacter Klebsiella Kluyvera Citrobacter Cit. Simmons Enterobacter Klebsiella Kluyvera Citrobacter + + - E. coli 10/31/2020 VP + Salmonella Serratia Proteus/Prov. (V) Shigella Morganella Shigella Salmonella Serratia Proteus Providencia Morganella Cit. Simmons
- Slides: 53